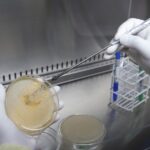

|
Getting your Trinity Audio player ready...
|
- El Gobierno libertario autorizo el autodespacho de combustible y habilito a las empresas a implementarlo “en forma total o instalar solo algunos surtidores”.
- Los playeros salteños advirtieron despidos y remarcaron que ellos hacen capacitaciones de manipulación y seguridad para no cometer errores.
A través del Decreto 46/2025 el gobierno de Javier Milei autorizo el autodespacho de combustible en todo el país. La medida habilita a las empresas expendedoras a implementar el servicio de “en forma total o instalar en su establecimiento solo algunos surtidores”.
Para concretar el autodespacho las expendedoras deberán pedir autorización a la Secretaria de Energía que conduce Maria Tettamanti, cuya área depende del Ministerio de Economía a cargo de Luis “Toto” Caputo.
El organismo de Tettamanti establecerá las condiciones de seguridad para que una empresa obtenga el permiso de implementar el autodespacho de combustibles. El decreto resalta que, con esta medida, las estaciones de servicio podrán ofrecer el servicio todo el día, lo que abarata el costo empresarial.
Por su puesto, la Confederación de Entidades del Comercio de Hidrocarburos de la República Argentina (CECHA) celebró la iniciativa del Gobierno porque “contribuye a momentos críticos que sufren las estaciones de servicio, como los feriados”. “No hay riesgo de puestos de trabajo, al menos por el momento”, dijeron desde el sector.
Acerca de cómo funcionaría, el texto del Gobierno dice que “una vez terminado el suministro de combustible, se repondrá la tapa del tanque y se colgara la manguera en su lugar, cuidando de que no quede enganchada en algún saliente del vehículo”. Allí recién se podrá encender el motor del vehículo.

REACCIONES
La medida del gobierno libertario fue cuestionada en duros términos por el Sindicato de Obreros de Estaciones de Servicio (SOESGYPE) que lidera Carlos Acuña, un ex integrante de la mesa chica de la central obrera CGT.
Según declaraciones de Acuña, están en riesgo más de 65.000 puestos de trabajo, al tiempo que se le allana el camino a las petroleras para aumentar sus ganancias. “Esto no es un avance tecnológico. Ya se intentó en los años 90 y fracaso. La gente no está dispuesta a actuar como playero”, indicó.
“No creo que haya beneficio alguno ni para los trabajadores ni para los usuarios. Esta medida busca abaratar costos sin considerar el impacto social”, afirmó el secretario general del sindicato de los playeros a nivel país.
EL IMPACTO EN SALTA
En Salta también hubo réplicas. El dirigente Fabricio Pintado dijo en una entrevista con El Once TV que la medida no hace más que “golpear a la gente trabajadora” y puntualizó que el despacho de combustible requiere de una capacitación previa, pues sin ella aumenta el riesgo de accidentes.

De hecho, en la Legislatura salteña se presentó un proyecto de ley que prohíbe el autodespacho de combustibles. El mismo establece que las expendedoras deben ser “exclusivamente atendidas por el personal en relación de dependencia, debidamente capacitados sobre procedimientos y normas de seguridad para el expendio de combustibles por surtidor y actuación frente a situaciones de emergencia o incendio”, detalla Diputados.
El proyecto fue impulsado por las diputadas Gladys Paredes y Nancy Jaime y por los diputados Enzo Alabi, Daniel Segura y Gustavo Dantur. La medida fue apoyada por Sindicato Unido de Petroleros e Hidrocarburiferos (SUPEH) durante un encuentro realizado a mediados del año 2024.
La habilitación del autodespacho impuesta por el Gobierno de Milei ha generado controversias en el mundo judicial por su aplicabilidad y, además, despertó el malestar de los trabajadores que se encargan de esta labor diariamente en las miles de estaciones de servicio del país. Según trascendidos a nivel nacional, habrá una medida de fuerza prontamente.

Leave a comment